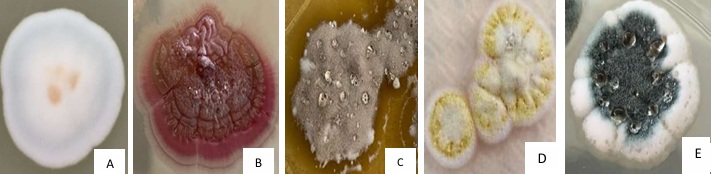
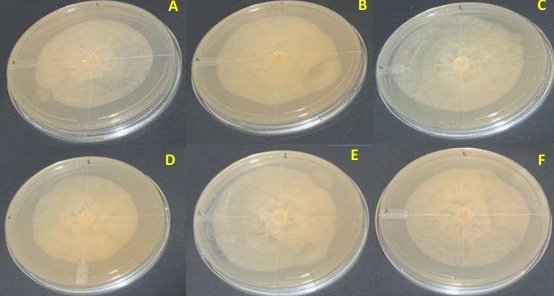
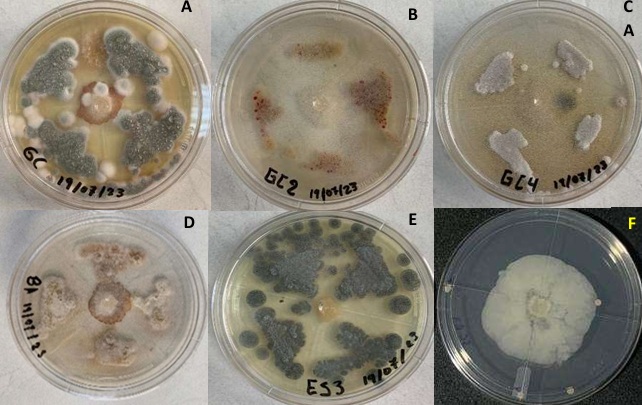

Introducción
El cacao (Theobroma cacao L.) es el producto agroalimentario de origen neotropical de mayor penetración en el mercado internacional y sus exportaciones en grano han representado más del 71% de volumen producido (Córdova, Campoverde, Unda, Montealegre y Romero, 2021). Sin embargo, esta producción en el cacao ecuatoriano ha disminuido por efecto de plagas como la monilia, escoba de bruja y mazorca negra (Aini, Sulistyowati, Oktaviana y Wulandari, 2020). La mazorca negra de cacao (Phytophthora palmivora), en particular, es un problema económicamente grave en todas las áreas del mundo donde se cultiva cacao, lo que provoca pérdidas significativas de mazorcas de hasta el 30% y mata hasta el 10% de árboles anualmente. (Montesino, Rosales y Castillo, 2021).
La mazorca negra del cacao representa una amenaza significativa por la reducción drástica en el rendimiento de los cultivos y la pérdida de calidad en el grano. Las estimaciones recientes indican que P. palmivora puede causar hasta un 70% de pérdida en el rendimiento de las cosechas en áreas gravemente afectadas (Winters et al., 2024). Económicamente, los daños atribuibles a esta enfermedad generan pérdidas millonarias anuales, afectando tanto a pequeños agricultores como a grandes plantaciones. Ecológicamente, la utilización intensiva de fungicidas para controlar la mazorca negra puede llevar a la degradación de los ecosistemas y la resistencia de los patógenos, exacerbando el problema a largo plazo (Ons, Bylemans, Thevissen y Cammue, 2020).
Con las nuevas regulaciones y restricciones en el empleo de plaguicidas y demanda de productos orgánicos, crece el interés por utilizar nuevas alternativas a los fungicidas para el manejo de enfermedades. Por ejemplo, el empleo de bacterias del suelo puede ser una alternativa al manejo de agroquímicos (Olaniyan y Adetunji, 2021). Un grupo interesante de bacterias para este fin serían los actinomicetos, que son abundantes y cosmopolitas en el ambiente. Además, son aerobios y se ubican en la superficie del suelo, aunque también viven en horizontes inferiores, en especial en suelos alcalinos (Bermejo, Castro, Hilacondo y Quispe, 2020). Dentro de sus características particulares presentan un olor típico a suelo húmedo por la producción de un metabolito llamado geosmina (Farda, Djebaili, Vaccarelli, Del Gallo y Pellegrini, 2022). Es importante resaltar que, la mayoría de los antibióticos conocidos han sido aislados a partir de actinomicetos (Bouizgarne, 2022). Algunas cepas han sido evaluadas como promotores de crecimiento vegetal, colocándose algunas como rizobacterias de tipo PGPR (Plant Growth Promoting Rhizobacteria) (Castaño, Durango, Echeverry y Arias, 2021).
Por lo anterior, el presente trabajo tiene como objetivo seleccionar actinomicetos con actividad antagónica al crecimiento de P. palmivora mediante evaluación in vitro (enfrentamientos duales) e in situ (sobre mazorcas de cacao). Este estudio ofrece varias ventajas significativas para la producción de cacao y la seguridad alimentaria. La utilización de estos actinomicetos no solo presenta una alternativa ecológica a los fungicidas químicos, reduciendo su impacto ambiental y minimizando el riesgo de desarrollo de resistencia, sino que también promueve un enfoque más sostenible y eficiente para el control de enfermedades en cultivos de cacao. La identificación y aplicación de estos microorganismos antagonistas podrían resultar en una reducción sustancial en las pérdidas de cosechas, mejorando así el rendimiento y la calidad del cacao. Además, al disminuir la dependencia de productos químicos, este enfoque contribuye a la salud del suelo y la biodiversidad, facilitando un sistema agrícola más resiliente y sostenible. En conjunto, estas mejoras no solo optimizan la producción de cacao, sino que también fortalecen la seguridad alimentaria global al asegurar una oferta estable y de alta calidad para los mercados internacionales.
Materiales y Métodos
Localización
La investigación se realizó en los laboratorios de Microbiología y Biotecnología de la Universidad Técnica Estatal de Quevedo (UTEQ), localizado en el Campus Universitario “La María", cantón Mocache, provincia Los Ríos, Ecuador (01º 04’ 51” S; 79º 30’ 08” O).
Diseño experimental. Se aplicó un Diseño Completamente al Azar (DCA) para evaluar el efecto antagónico de las cepas sobre el fitopatógeno Phytophthora palmivora (in vitro) y sobre mazorcas de cacao (in situ). Para los experimentos in vitro se emplearon seis tratamientos constituidos por los cinco actinomicetos BA; GC; GC2; GC4; ES3 y un grupo control. En el ensayo in situ se utilizaron cuatro cepas de actinomicetos: BA; GC2; GC4 y ES3. Las cepas corresponden a las cepas aisladas a partir de muestras de rizósfera de cacao. Todos los tratamientos se realizaron en tres repeticiones y un grupo control para cada bioensayo.
Análisis estadístico. Las variables fueron sometidas a un Análisis de Varianza (ADEVA), para determinar el efecto de los tratamientos. Previamente se determinaron las pruebas de normalidad y homogeneidad de varianza. Para determinar las diferencias entre los tratamientos se utilizó la prueba de Duncan. Todos los análisis se llevaron a cabo en el software estadístico SPSS versión 25 (IBM SPSS Statistics, 2017).
Manejo del Experimento
Toma de muestra y aislamiento de actinomicetos rizosféricos. Las muestras fueron recolectadas en rizósfera de cultivos de Theobroma cacao. La muestra se colocó en bolsas estériles de polietileno, que fueron transportadas en hielera y condiciones asépticas al laboratorio de Microbiología de la Universidad Técnica Estatal de Quevedo.
En el laboratorio se pesaron 10 g de suelo que se dejó secar durante 24 h a temperatura ambiente. Luego se pesó 1 g de la muestra seca y se mezcló en 9 mL de agua destilada estéril. Esta mezcla fue agitada por 30 min a 150 rpm. Luego se prepararon tubos eppendorf estériles con 900 µL de agua destilada estéril y 100 µL de la solución con las muestras de suelo para realizar diluciones desde 1×101 hasta 1×106. Estas muestras se sembraron en medio de cultivo ISP2 (Mendoza-Herrera et al., 2020). El medio se preparó a partir de los siguientes reactivos: bacto-yeast extract 4.0 g, bacto-malt extract 10.0 g, bacto-dextrose 4.0 g, agua destilada 1.0 L, y luego se agregó agar-agar 20.0 g y se ajustó el pH a 7.0. Al solidificarse el medio, se tomaron 20 µL de cada dilución con una micropipeta, y se ubicó en el centro de la placa Petri. La suspensión bacteriana se distribuyó sobre la superficie del agar mediante el método de dispersión utilizando el asa de Drigalsky para esparcir el inóculo de manera uniforme. Las cajas Petri se dejaron incubar a 28 °C durante 15 días, revisándolas a cada dos días. Para la purificación de colonias de actinomicetos se utilizó el medio de cultivo ISP-2, suplementado con nistatina (50 μL mL-1), itraconazol (50 μg mL-1) y fosfomicina (50 μg mL-1) para evitar la proliferación de bacterias y crecimiento de hongos no deseados.
Caracterización morfológica. La caracterización de los actinomicetos se basó de acuerdo con su morfología. Se eligieron las cajas con colonias que presentaban características como textura, formación de geosmina y producción de pigmentos los cuales varían desde el blanco, gris hasta el crema, verde y café. Los actinomicetos observados fueron comparados con los descritos en el Manual de Determinación Bacteriológica de Bergey (He et al., 2020).
Caracterización bioquímica. Se utilizó el método de tinción Gram y posteriormente se observó en el microscopio para determinar por el color si las bacterias eran Gram positivas (color azul/violeta) o Gram negativas (color rojo/rosado) (Djebaili, et al., 2020). Además, se hizo la prueba de catalasa a las cepas de actinomicetos puras y jóvenes, añadiendo sobre la colonia una gota de peróxido de hidrógeno H2O2 al 30 % (v/v). Una interpretación positiva mostraría la formación de burbujas (O2) (Javed, Tripathi, Mishra, y Dashora, 2021).
Reactivación de actinomicetos en medio líquido. Para la reactivación de actinomicetos en medio líquido se utilizó el medio ISP2. Brevemente, después de preparar el medio líquido se incluyó una mezcla de antibióticos (fosfomicina, itraconazol y nistatina), para evitar la contaminación y asegurar el crecimiento de los actinomicetos. Posteriormente se inocularon las bacterias a partir de un cultivo sólido fresco. Se sometió a agitación constante (150 rpm) durante 7-15 días para su crecimiento.
Preservación de actinomicetos. Se preservaron en tubos eppendorf (800 μL de medio ISP2 y 200 μL de glicerina) a -40 °C para su posterior estudio.
Obtención de metabolitos. Para el desarrollo del ensayo se tomaron cepas puras de actinomicetos, haciéndolas crecer en matraz con medio ISP2 líquido, durante 15 días en agitación (150 rpm) a temperatura ambiente. Luego se colocaron en tubos Falcon de 50 mL y se centrifugaron a 3000 rpm durante 20 min tres veces para separar la fase sólida de la líquida descartando la sólida. Se realizó el choque térmico del sobrenadante colocándolo en refrigeración a -40 ºC durante 15 min y luego en baño maría a 60 °C durante 15 min, repitiendo el procedimiento 3 veces hasta dejar el sobrenadante libre de células. Después de este proceso se realizó el filtrado (filtros de 0.2 µm) para asegurar la presencia de los metabolitos solamente.
Reactivación y conservación de Phytophthora palmivora. Las cepas de P. palmivora se obtuvieron del banco de germoplasma del laboratorio de Microbiología y Biotecnología de la UTEQ. La cepa seleccionada se sometió a una reactivación. Siguiendo los postulados de Koch se tomó la cepa de P. palmivora y se infectó a una mazorca sana. Siguiendo la metodología de Auhin-Arcos et al. (2021), se recolectaron mazorcas de cacao sanas de la variedad CCN-51 con 18 semanas de edad. Se lavaron con agua destilada y jabón, para luego sumergirlas en NaClO al 10% durante 10 s. La incubación de la cepa se mantuvo en cámara húmeda. Se tomaron discos miceliales del tubo eppendorf donde estaba conservada la cepa matriz y se sembró en los extremos de la mazorca (sección en donde se realizaron pequeños cortes). El periodo de incubación fue de 3 días. Al observar que la mazorca se afectó con la enfermedad causada por este hongo, se aisló el patógeno en un medio de cultivo (agar V8), específico para P. palmivora. Para la conservación se recolectaron pequeños discos de agar 1 cm Ø colocándolos en tubos eppendorf que contenían 1 mL de agua estéril.
Antagonismo in vitro de los metabolitos de los actinomicetos frente a Phytophthora palmivora. Para este ensayo se obtuvo el extracto celular de cinco cepas de actinomicetos previamente caracterizadas, y se utilizó el medio agar V8 ya que favorece el crecimiento y desarrollo de P. palmivora. En el medio de cultivo se sembraron 20 µL de extractos celulares de los actinomicetos, esparcidos por toda la placa, y luego se colocó un tarugo de 5 × 5 mm de P. palmivora en el centro de cada placa. Se evaluó el crecimiento de P. palmivora con relación al control que solo tenía medio con el patógeno por 5 días. Este ensayo también se realizó sumergiendo pequeños discos de papel filtro de 5 mm por 20 s en el extracto celular de cada cepa, cuatro discos por tratamiento. Seguidamente, se colocó a P. palmivora en los cuatros puntos cardinales de la placa y en el centro.
Antagonismo in vitro de celulas de actinomicetos frente a Phytophthora palmivora . La prueba de antagonismo se realizó por el método de enfrentamiento dual. Brevemente, se empleó el medio de cultivo PDA favorable para los actinomicetos y P. palmivora y se utilizaron cinco cepas de actinomicetos previamente purificadas y caracterizadas. En cada placa se colocaron cuatro discos de agar (5 × 5 mm) de las cepas de actinomicetos crecidas en medio ISP2 sólido, uno en cada punto cardinal, a 2 cm del centro de la placa, y un disco de agar con P. palmivora en el centro de la placa. Se observó el crecimiento entre microrganismos y se evaluó durante 6 días para observar la inhibición bacteria-patógeno.
Antagonismo in situ de los metabolitos de actinomicetos frente a Phytophthora palmivora. Se colocaron discos de agar (5 × 5 mm) de P. palmivora a los extremos de la mazorca. Los extractos celulares de los actinomicetos (5 mL) se colocaron por aspersión por toda la mazorca y se evaluó el extracto celular de tres cepas de actinomicetos durante 4 días.
Antagonismo in situ de celulas de actinomicetos frente Phytophthora palmivora. Se sembraron discos (5 × 5 mm) de P. palmivora en los extremos de la mazorca. Los actinomicetos se colocaron por aspersión de medio líquido ISP2 (5 mL), después de 15 días de reactivación. Se evaluaron cuatro cepas de actinomicetos durante 6 días.
Variables Evaluadas
Porcentaje de inhibición in vitro del crecimiento micelial de P. palmivora con actinomicetos rizosféricos y sus metabolitos. Se evaluó el crecimiento radial del hongo utilizando un calibrador Vernier. La inhibición producida por los actinomicetos se midió hasta 6 días después de la inoculación, mientras que la inhibición causada por los metabolitos se evaluó hasta 5 días después de la inoculación. Se calculó el porcentaje con la siguiente fórmula:
Donde: % inhibición = Porcentaje de inhibición del crecimiento del patógeno, Crecimiento del testigo = Radio de la colonia del patógeno (cm), Crecimiento del tratamiento = Radio de la colonia patógena que crece hacia el agente antagonista (cm).
Porcentaje de inhibición in situ del crecimiento micelial de P. palmivora con actinomicetos rizosféricos y sus metabolitos. Se evaluó el crecimiento micelial del hongo sobre mazorcas de cacao utilizando un calibrador Vernier. La medición se realizó durante 6 días para los tratamientos con actinomicetos y durante 4 días para los tratamientos con metabolitos. Además, se aplicó la fórmula previamente descrita para calcular el porcentaje de inhibición.
Severidad de la enfermedad. La severidad se calculó utilizando una escala arbitraria que estima el porcentaje de daño de la mazorca de cacao (Figura 1).
Resultados y Discusión
Aislamiento y caracterización de actinomicetos rizosféricos. Se aislaron cinco cepas puras de actinomicetos rizosféricos. Cada cepa de actinomiceto presentó una morfología diferente. Se observó diversidad de pigmentos en las cepas, que van desde blanco, crema, amarillo, marrón, verde, etc. En cuanto a la textura, presentaron características propias de actinomicetos como textura seca, polvosa y adheridas al agar (Cuadro 1). Además, hubo cepas con texturas acuosas posiblemente de geosmina (Figura 2). Adicionalmente, mediante la caracterización bioquímica, todas las cepas fueron Gram positivas y presentaron la capacidad de hidrolizar el peróxido de hidrógeno (catalasa positiva).
Cuadro 1: Características morfológicas de actinomicetos aislados de la rizósfera de cultivos de cacao (Theobroma cacao) en Ecuador.
Table 1: Morphological characteristics of actinomycetes isolated from the rhizosphere of cocoa (Theobroma cacao) in Ecuador.
| Cepa | Textura | Coloración |
| GC | Con geosmina, esponjosa | Blanca |
| GC2 | Filamentosa, rígida | Rojiza |
| GC4 | Blanda con geosmina | Gris |
| BA | Seca con presencia de geosmina | Amarilla con Blanco |
| ES3 | Polvosa con geosmina | Verde oscuro |
Efecto antagonista in vitro de los metabolitos de los actinomicetos sobre P. palmivora. Con los metabolitos obtenidos de los actinomicetos rizosféricos se observaron diferencias significativas entre los tratamientos (Figura 3). Todos los tratamientos reflejaron inhibición de P. palmivora respecto a la media, sobresaliendo el tratamiento GC2 (16.42 %) y ES3 (13.67 %) a diferencia del resto de las cepas. Las cinco cepas de actinomicetos (cepa ES3, cepa GC4, cepa GC, cepa GC2, cepa BA) presentaron antagonismo frente a P. palmivora mostrando mayor inhibición del crecimiento con respecto al control, donde se observó que el crecimiento del micelio del hongo disminuyó respecto al grupo control (Figura 4).
Efecto antagonista in vitro de las celulas de actinomicetos con P. palmivora. En el enfrentamiento dual de P. palmivora con los actinomicetos sembrados en sólido, todas las cepas registraron una disminución del crecimiento del patógeno, sin embargo, no se encontraron diferencias significativas entre los tratamientos. Se destacó la cepa ES3 con la inhibición al desarrollo micelial de 74.08%, en comparación con la cepa GC4 (45.75%) (Figura 5). Las cinco cepas de actinomicetos aisladas presentaron antagonismo frente a P. palmivora mostrando mayor inhibición del crecimiento con respecto al control, donde se observó que el crecimiento del micelio del hongo disminuyó hacia la colonia del actinomiceto. A partir de ese momento, el patógeno detuvo su crecimiento por la actividad antagónica de los actinomicetos (Figura 6).
Efecto antagonista de los metabolitos de actinomicetos frente a P. palmivora en mazorcas de CCN-51. Los metabolitos obtenidos de actinomicetos rizosféricos se aplicaron en mazorcas de cacao CCN-51 y registraron una disminución del crecimiento del patógeno, mostrando diferencias entre los tratamientos. La cepa GC2 mostró una mayor inhibición del patógeno (63%) (Figura 7). Se observó la inhibición de P. palmivora en mazorcas de cacao que contenían los metabolitos de tres cepas de actinomicetos (cepa ES3, cepa GC2, cepa BA) más el control. La mazorca con la cepa GC2 reflejó un menor crecimiento del patógeno relacionado con la mazorca control que solo contenía P. palmivora. Al realizar un corte transversal en cada una de las mazorcas se observó la inhibición en el interior de la mazorca de cacao CCN-51 (Figura 8).
Figura 7: Porcentaje (%) de inhibición de los metabolitos de actinomicetos frente a Phytophthora palmivora en mazorcas de cacao CCN-51 evaluadas a los 4 días. Las barras de error indican ± desviación estándar; diferentes letras indican diferencias significativas entre los promedios a P < 0.05 (test de Duncan).
Efecto antagonista en mazorcas de cacao CCN-51 de las células de actinomicetos sobre P. palmivora. Se encontraron diferencias significativas en la aplicación de células de actinomicetos en mazorcas de cacao en comparación con el control que solo contenía el patógeno. Todas las cepas mostraron capacidad de inhibir el crecimiento de P. palmivora. El mayor porcentaje de inhibición se observó con el tratamiento GC2 (36 %), en comparación con GC4 (15 %) (Figura 9). El efecto negativo de P. palmivora en mazorcas de cacao disminuye con el tratamiento de actinimicetos sobre la mazorca, particularmente con las cepas ES3 y GC2 (Figura 10).
Figura 9: Porcentaje (%) de inhibición de células de actinomicetos rizoféricos frente a Phytophthora palmivora en mazorcas de cacao CCN-51 evaluadas a los 6 días. Las barras de error indican ± desviación estándar; diferentes letras indican diferencias significativas entre los promedios a P < 0.05 (test de Duncan).
Severidad de la enfermedad. La severidad de la enfermedad fue menor en todos los tratamientos respecto al control (Cuadro 2). Particularmente, el tratamiento GC2 tuvo el menor porcentaje de severidad de la enfermedad en la mazorca. También destacó el tratamiento ES3, con menos severidad para los días 5 y 6 respecto al control.
Cuadro 2: Porcentaje de severidad de la mazorca negra (Phytophthora palmivora) en mazorcas de cacao tratadas con actinomicetos rizosféricos. Porcentaje de severidad de la enfermedad durante los 6 días de infestación.
Table 2: Percentage severity of black ear (Phytophthora palmivora) in cocoa pods treated with rhizospheric actinomycetes. Percentage of disease severity at 6 days of infestation.
| Tratamientos | |||||
| GC2 | GC4 | ES3 | BA | Control | |
| Día 1 | 0 | 0 | 0 | 0 | 0 |
| Día 2 | 7 | 5 | 15 | 20 | 25 |
| Día 3 | 27 | 25 | 27 | 30 | 40 |
| Día 4 | 40 | 30 | 40 | 40 | 50 |
| Día 5 | 51 | 70 | 53 | 55 | 75 |
| Día 6 | 55 | 75 | 58 | 60 | 83 |
En este estudio, se caracterizaron un total de cinco cepas de actinomicetos rizosféricos. La diversidad observada en morfología y pigmentación entre las cepas de actinomicetos podría ser el resultado de una combinación de factores genéticos, ambientales y de interacciones con el entorno. Estos resultados sugieren una rica diversidad dentro de la comunidad de actinomicetos rizosféricos y pueden tener implicaciones importantes para la actividad antagonista contra P. palmivora (He et al., 2020). El hecho de que todas las cepas de actinomicetos aisladas en este estudio sean Gram positivas y muestren capacidad para hidrolizar el peróxido de hidrógeno (catalasa positiva), sugiere que estos actinomicetos tienen características que las hacen adaptables y potencialmente beneficiosos para las plantas en su entorno rizosférico (Bouizgarne, 2022). Trabajan como PGPR además de producir compuestos bioactivos capaces de inhibir el crecimiento de fitopatógenos, siendo relevante para su potencial aplicación en la agricultura y la protección de cultivos. Con el propósito de evaluar el potencial de dos cepas de actinomicetos Streptomyces sp. (EA2 y B8) como promotoras del crecimiento inicial de plántulas de Nicotiana tabacum L., García-Bernal et al. (2025) reportaron incrementos en las variables morfométricas de parte aérea y raíz cuando se aplicaron las cepas EA2 y B8 de Streptomyces sp., las cuales poseen características de BPCV, confirmando que, la combinación de esas cepas son una alternativa segura y eco-amigable con potencial para disminuir la aplicación de agroquímicos en N. tabacum L.
Además, cuando se observaron los actinomicetos al microscopio se encontraron formas filamentosas. Esto concuerda con los resultados obtenidos por Farda et al. (2022), quienes también aprecian formas filamentosas, siendo características particulares de los actinomicetos según describe Yandigeri (2021). También se comparó con el manual de Lahmyed et al. (2021) quienes mencionan que tales características pertenecen al género Streptomyces.
La falta de efecto significativo en el crecimiento micelial de P. palmivora y el porcentaje de inhibición con metabolitos de actinomicetos rizosféricos in vitro puede ser atribuible a una combinación de factores, incluida la concentración de los metabolitos, la variabilidad entre cepas de actinomicetos y la posible resistencia intrínseca de P. palmivora. Morales-Pizarro et al. (2022) obtuvieron metabolitos de cepas de actinomicetos con dos solventes, el acetato de etilo y el diclorometano, y la actividad antimicrobiana fue evidente tanto para las bacterias como los hongos patógenos de la papa. Esto indica que con ayuda de un solvente para la recuperación de metabolitos bioactivos de actinomicetos se potencia el efecto de los extractos. Mendoza-Herrera et al. (2020) mencionan que Streptomyces inhibe el crecimiento micelial de fitopatógenos habitantes del suelo mediante antibiosis de compuestos no volátiles. Dávila-Medina, Gallegos, Hernández, Ochoa y Flores (2013) describieron mecanismos de Streptomyces lydicus a través de antifúngicos y quitinasa extracelular que destruye no solo las esporas, también dañan la pared celular de las hifas. Por otra parte, la falta de una identificación a nivel molecular de las cepas aisladas limita la inferencia de los resultados obtenidos. Sin embargo, los resultados concuerdan con los obtenidos por Djebaili, et al. (2021), quienes a nivel in vitro evidenciaron un significativo potencial de las cepas como agentes de control biológico de P. capsici, al presentar diferencias significativas en la inhibición del crecimiento micelial de dicho patógeno.
La aplicación de metabolitos de actinomicetos rizosféricos en mazorcas de cacao CCN-51, evidenciaron una disminución en el crecimiento del patógeno, lo que indica que estos extractos tienen un efecto inhibitorio sobre P. palmivora. Cada cepa de actinomiceto puede producir una combinación única de estos compuestos bioactivos, lo que puede explicar las diferencias en la actividad antagonista observada entre las cepas. Respecto a esto, Javed et al. (2021) describen que la mayoría de los compuestos bioactivos sintetizados por actinomicetos corresponden a diversas estructuras químicas, como aminoglucósidos (estreptomicina y kanamicina), glicopéptidos (vancomicina), macrólidos (eritromicina), β-lactámicos (penicilinas, cefalosporinas), nucleósidos (puromicina), péptidos de síntesis no ribosomal (gramicidina, bacitracina), policétidos (actinorrudina, anfotericina), entre otros. Sin embargo, es importante destacar que la identificación y caracterización específica de los compuestos bioactivos presentes en los metabolitos requeriría técnicas analíticas avanzadas como la cromatografía en capa fina (Hue, Mai, Van, Minh y Thao, 2020) que se deberían aplicar en próximos estudios.
Los bioactivos producidos por actinomicetos exhiben una amplia variedad de efectos biológicos, incluyendo actividad antibacteriana y antifúngica, interferencia en la síntesis de proteínas y de la pared celular, alteración de la permeabilidad de membranas, así como propiedades antitumorales, antiinflamatorias y antivirales (Kontro, Yaradoddi, Ganachari, Banapurmath y Umesh, 2022). Por ello, son un referente de gran importancia para el tratamiento y manejo de cultivos de importancia económica afectados por enfermedades tropicales. La disminución del crecimiento del patógeno sugiere que estas cepas de actinomicetos poseen la capacidad de inhibir el crecimiento de P. palmivora. Por su parte, Dede, Güven y Şahin (2020) revelaron que las cepas de actinomicetos aisladas inhibieron completamente el crecimiento del tizón de halo en fréjol (Pseudomonas syringae pv. Phaseolicola). Respecto a esto, se considera que las actinobacterias o comúnmente llamadas actinomicetos, de acuerdo Patel-Ishita et al. (2021), han demostrado su potencial in vitro como antagonistas para diferentes especies de Phytophthora. Esto es fundamentado por Fadhilah, Santoso, Maryanto, Abdullah y Yasman (2021), quienes indican que estos microorganismos tienen la capacidad de inhibir o reducir el crecimiento de fitopatógenos a través de mecanismos directos e indirectos como la producción de antibióticos, enzimas líticas, hiperparasitismo, competencia y la inducción de resistencia sistémica en las plantas.
La ausencia de diferencias significativas en el crecimiento de P. palmivora en mazorcas de cacao CCN-51 inoculadas con las cepas (ES3, GC2, GC4 y BA) en comparación con el control podría atribuirse a diversos factores intrínsecos al sistema biológico y al diseño experimental. Uno de los aspectos cruciales es la necesidad de una colonización efectiva del tejido vegetal por parte de los actinomicetos para que puedan ejercer su actividad antagonista. Como señalan Whipps (2001) en su revisión sobre estrategias de biocontrol microbiano, la eficacia de los agentes de biocontrol depende en gran medida de su capacidad para establecerse y proliferar en el sitio de interacción con el patógeno. Además, la concentración del agente de biocontrol, la dosis aplicada y el método de aplicación son parámetros críticos que influyen directamente en la capacidad del microorganismo para inhibir el crecimiento del patógeno (Tyagi et al., 2024). Estos factores pueden haber limitado la interacción efectiva entre las cepas de actinomicetos y P. palmivora en el contexto experimental, impidiendo la manifestación de un efecto antagónico significativo. Como menciona Yuvaraj et al. (2023), la interacción entre las plantas, los microorganismos y los patógenos puede estar influenciada por factores como la composición del suelo, la disponibilidad de nutrientes y otros elementos.
Los resultados obtenidos durante el periodo de observación revelaron una inhibición significativa en la progresión de la enfermedad en las mazorcas tratadas, con una reducción de la severidad de hasta el 55%, con la cepa GC2, al sexto día post-inoculación, en contraste con el grupo control donde la severidad superó el 83%. Esta marcada disminución sugiere un efecto inhibitorio consistente de las cepas de actinomicetos evaluadas sobre el patógeno Phytophthora palmivora, en este sentido, Nysanth et al. (2022) demostraron la capacidad de actinomicetos aislados del suelo de la rizósfera de pimienta negra para controlar Phytophthora palmivora. Los resultados demostraron que varios aislamientos de actinomicetos exhibieron una significativa actividad antifúngica in vitro contra P. palmivora y también mostraron potencial para reducir la incidencia de la pudrición del pie en experimentos in vivo.
La capacidad de microorganismos para antagonizar el crecimiento de fitopatógenos es un fenómeno bien documentado y representa una estrategia prometedora para el manejo sostenible de enfermedades en la agricultura (Whipps, 2001). Los mecanismos involucrados en esta inhibición pueden ser diversos, incluyendo la competencia por nutrientes y espacio, la producción de metabolitos antimicrobianos, el parasitismo directo y la inducción de resistencia en la planta huésped (Glick, 2012). Es crucial reconocer que la respuesta a los agentes de biocontrol puede estar influenciada por una compleja interacción de factores ambientales, como la temperatura y la humedad, así como por la variabilidad genética tanto del patógeno como del hospedante (Möller y Stukenbrock, 2017; Hokkanen y Hajek, 2003). Por lo tanto, la consistencia y la magnitud del efecto inhibitorio podrían variar bajo diferentes condiciones de campo.
En este contexto, futuras investigaciones deberían enfocarse en dilucidar los mecanismos específicos a través de los cuales las cepas de actinomicetos ejercen su actividad antagónica contra P. palmivora. La identificación de los metabolitos bioactivos producidos por los actinomicetos (Selim, Abdelhamid y Mohamed, 2021; Yanti, Hamid, Dzulfahmi, Selviana y Putra, 2023; Oyedoh et al., 2023) o la comprensión de la inducción de mecanismos de defensa en la planta (Pieterse et al., 2014), podrían abrir nuevas vías para el desarrollo de estrategias de biocontrol más eficientes y específicas. Además, la evaluación del desempeño de estas cepas bajo diversas condiciones agroecológicas y en diferentes genotipos de cacao es fundamental para su implementación exitosa a nivel de campo.
Conclusiones
En conclusión, la presente investigación ha demostrado el potencial significativo de los actinomicetos rizosféricos aislados de cultivos de cacao ecuatorianos como agentes de biocontrol contra el patógeno Phytophthora palmivora, causante de la devastadora mazorca negra. Los resultados obtenidos in vitro revelaron una variabilidad en la capacidad antagónica entre las cepas, destacándose la cepa ES3 por su elevada inhibición del crecimiento micelial del patógeno. No obstante, los ensayos con los metabolitos de los actinomicetos y, crucialmente, las pruebas in situ sobre mazorcas de cacao, señalaron a la cepa GC2 como la más promisoria, logrando una reducción sustancial en la severidad de la enfermedad.
Estos hallazgos sugieren que los actinomicetos rizosféricos, y en particular la cepa GC2, representan una alternativa ecológica y sostenible para el manejo de la mazorca negra del cacao en Ecuador. Si bien se requiere de investigaciones futuras para optimizar su aplicación a nivel de campo y comprender a profundidad los mecanismos de acción involucrados, este estudio sienta una base sólida para el desarrollo de estrategias de biocontrol que contribuyan a la protección de los cultivos de cacao y a la mejora de la calidad del grano, beneficiando a los productores y a la economía del país.
Financiación
El proyecto se realizó con recursos del proyecto FOCICYT de la novena convocatoria titulado “Actinomicetos con potencial biotecnológico en el cultivo de cacao (Theobroma cacao L.)”, de la línea de investigación: Agricultura, Silvicultura y Producción animal, de la Universidad Técnica Estatal de Quevedo.